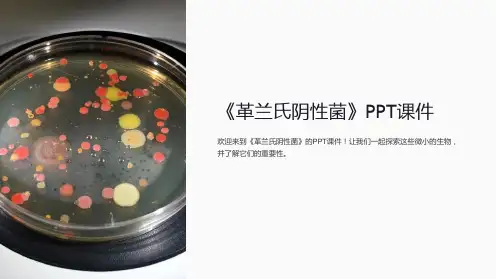

革兰氏阴性菌ppt课件
- 格式:ppt
- 大小:3.12 MB
- 文档页数:3




革兰氏阳性细菌与阴性细菌得比较把细菌采用龙胆紫染色,涂碘加强染色。
然后用酒精脱色,革兰氏阳性菌不会被脱色呈现紫色,革兰氏阴性菌会被脱色呈现红色、在治疗上,大多数革兰氏阳性菌都对青霉素敏感;而革兰氏阴性菌则对青霉素不敏感,而对链霉素、氯霉素等敏感。
革兰氏染色法得意义就在于鉴别细菌,把众多得细菌分为两大类,革兰氏阳性菌与革兰氏阴性菌。
大多数化脓性球菌都属于革兰氏氏阳性菌,它们能产生外毒素使人致病,而大多数肠道菌多属于革兰氏阴性菌,它们产生内毒素,靠内毒素使人致病。
常见得革兰氏阳性菌有:葡萄球菌(Staphylococcus)、链球菌(Streptococcus)、肺炎双球菌、炭疽杆菌、白喉杆菌、破伤风杆菌等;常见得革兰氏阴性菌有痢疾杆菌、伤寒杆菌、大肠杆菌、变形杆菌、绿脓杆菌、百日咳杆菌及霍乱弧菌等。
1、阳性得肽聚糖厚,阴性得肽聚糖薄,如下图:2、阳性菌有磷壁酸,阴性菌没有。
磷壁酸如下图:3.阳性菌无外膜,阴性菌有外膜,其图如下:1884年革兰氏染色法被发明,用于细菌得形态观察与分类,根据革兰氏染色反应得基本特征,细菌可以主要分为两大类:G阳性(G+)与G阴性(G-)。
前者经过染色后细菌细胞仍然保留初染结晶紫得蓝紫色,后者经过染色后细菌细胞则先脱去了初染结晶紫得颜色,带上了复杂蕃红或沙黄得红色。
本文将从细胞形态与结构,生理特性以及在生产生活中不同得运用这三个方面,来对革兰氏阳性细菌与阴性细菌进行进一步比较。
一、细胞形态与结构细胞得基本结构包括细胞壁与原生质体两部分、原生质体位于细胞壁内,包括细胞膜(细胞质膜)、细胞质、核质与内含物、另外细胞还含有有些特殊结构,主要有荚膜、芽孢、鞭毛与菌毛等4种。
由于革兰氏阳性细菌与阴性细菌在结构上得差别主要在于细胞壁,故本文就细胞壁与非细胞壁结构两部分来进行集中比较、1.细胞壁革兰氏染色得机理主要就是抓住了革兰氏阳性细菌与阴性细菌在细胞壁得结构与组成上得不同,具体比较见下表:性多糖构成,细胞表面整体带负电得部分原因就就是因为磷酸壁带负电。